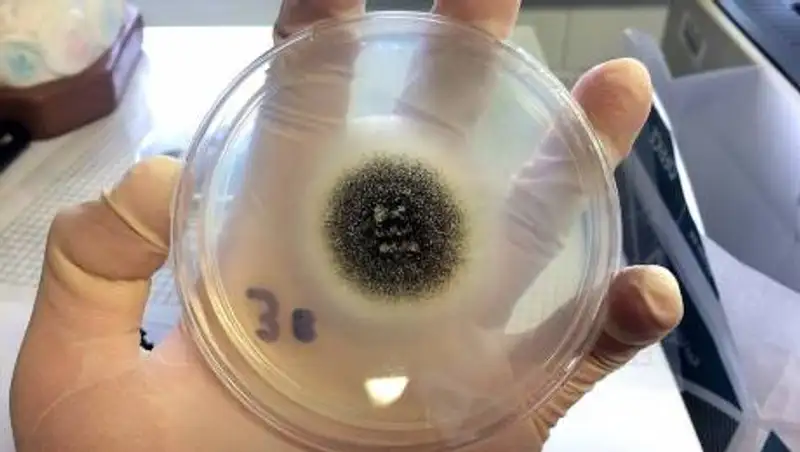
Врач развеял миф о смертельной опасности черной плесени

Врач развеял миф о смертельной опасности "черной плесени"
 pixabay.com
pixabay.com
Врач и телеведущий Евгений Комаровский развеял миф о смертельной опасности "новой индийской болезни" - "черной плесени", сообщает zakon.kz.
На своем YouTube-канале Комаровский опубликовал видеоролик под названием "Черная плесень - страшилка или реальная угроза?". В нем он рассказал, в каких случаях возможно заражение мукормикозом - заболеванием, которое вызывает "черная плесень".
Читайте также:
"Черная плесень" из Индии добралась до России
Существует четыре царства: растения, животные, бактерии, ну, и кончено, грибы. В царстве грибов есть отдел микромицеты, куда входят мукоровые грибы или их еще называют микромицеты. Эти грибы образуют плесень. Споры этой плесени могут контактировать с кожей, со слизистыми оболочками, их можно вдохнуть. В некоторых ситуация споры могут вызвать болезнь, которая называется мукоромикоз. У этого словам есть народные синонимы - "черная плесень" или "черный грибок". Евгений Комаровский
Читайте также:
Об эпидемии "черной плесени" объявили два индийских штата
Врач объяснил, когда человек может заболеть мукоромикозом.
Для этого необходимо сочетание нескольких факторов. Самое главное - это состояние иммунной системы. То есть для человека с нормальным иммунным статусом, с неповрежденной иммунной системой болезнь абсолютно невозможна: иммунная система моментально определит и нейтрализует споры грибов. Угнетение иммунитета возможно в силу определенных заболеваний: например, ВИЧ и СПИД. Появляются риски, если человек принимает препараты, которые угнетают иммунную систему. К таким относиться "Дексаметазон" или другие кортикостероиды, которые могут использоваться и для лечения коронавирусной инфекции. Евгений Комаровский
Читайте также:
В Индии обнаружили "желтую плесень" у пациента, перенесшего коронавирус
Когда "Дексаметазон" назначается в больших дозах и надолго - в таком ситуации на фоне угнетения состояния иммунной системы, возможно, наша система перестанет распознавать вот эти самые грибки (уметь с ними бороться). Но одного угнетения иммунной системы, на самом деле, мало. Сюда же следует отнести состояние, при котором нарушена микроциркуляция в коже и слизистой. Одним из наиболее опасных состояний является сахарный диабет второго типа, который не контролируется (который связан с ожирением). Евгений Комаровский
Читайте также:
В Ираке два человека умерли из-за "черной плесени"
Также, по его словам, состоянием, которое может способствовать заболеванию, является онкология.
Естественно, та, которая лечится с помощью химиопрепаратов, трансплантация органов, пересадка стволовых клеток, (...) любое состояние, когда снижено количество лейкоцитов в организме. (...) Также важны те факторы, которые имеют место в Индии. Например, дефицит белка в организме. Это происходит, когда люди мало кушают либо голодают. Развитию мукоромикоза может способствовать и высокий уровень железа в организме. Это может быть связано с приемом железа либо особенностями питания. Евгений Комаровский
Читайте также:
Летальные исходы от "черной плесени" зафиксированы еще в двух странах
Как подчеркнул врач, там, где заболевание имеет массовый характер, сочетаются все упомянутые факторы. Все это, по словам Комаровского, складывается вместе и получается вспышка "черной плесени".
Он посоветовал не принимать гормональные препараты без назначения врача, а также следить за уровнем сахара и железа. При работах на даче, как отметил врач, не стоит допускать прямого контакта кожи с почвой.
Мукоромикоз - это не смертельно, если вовремя диагностировать заболевание, если есть доступ к противогрибковым антибиотикам. Евгений Комаровский